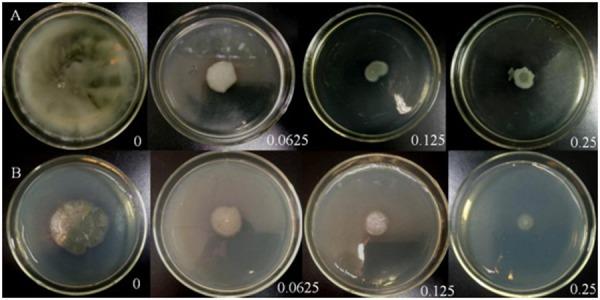
https://cdn.ncbi.nlm.nih.gov/pmc/blobs/9836/6451918/18cf35abfd2d/jvms-81-473-g004.jpg

连翘苷是一种有效的群体感应抑制剂,具有作为抗铜绿假单胞菌感染治疗药物的潜力。
Phillyrin is an effective inhibitor of quorum sensing with potential as an anti-Pseudomonas aeruginosa infection therapy.
作者信息
Zhou Shuxin, Zhang An, Chu Weihua
机构信息
Department of Pharmaceutical Microbiology, School of Life Science and Technology, China Pharmaceutical University, Nanjing 210009, China.
出版信息
J Vet Med Sci. 2019 Mar 30;81(3):473-479. doi: 10.1292/jvms.18-0523. Epub 2019 Jan 28.
In the present study, we evaluated the antibacterial and anti-quorum sensing qualities of phillyrin. The minimum inhibitory concentration (MIC) of phillyrin with regard to Pseudomonas aeruginosa is 0.5 mg/ml. The production of virulence factors-such as rhamnolipid (>78.69%), pyocyanin (>85.94%), and elastase (>89.95%)-that affect the pathogenicity of the P. aeruginosa strain PAO1 apparently declined in the presence of 0.25 mg/ml phillyrin. Biofilm formation decreased by 84.48%. In a Caenorhabditis elegans-Pseudomonas aeruginosa infection model, diseased worms lived longer (63.33%) in a phillyrin-containing medium than in a drug-free medium, and the drug did not directly kill the pathogen. Therefore, the present work suggests that phillyrin has potential as an antimicrobial agent for the control of infectious pathogens.
在本研究中,我们评估了连翘苷的抗菌和抗群体感应特性。连翘苷对铜绿假单胞菌的最低抑菌浓度(MIC)为0.5mg/ml。在存在0.25mg/ml连翘苷的情况下,影响铜绿假单胞菌PAO1菌株致病性的毒力因子(如鼠李糖脂(>78.69%)、绿脓菌素(>85.94%)和弹性蛋白酶(>89.95%))的产生明显下降。生物膜形成减少了84.48%。在秀丽隐杆线虫-铜绿假单胞菌感染模型中,患病线虫在含连翘苷的培养基中比在无药物培养基中存活时间更长(63.33%),并且该药物不会直接杀死病原体。因此,目前的研究表明连翘苷有潜力作为一种抗菌剂来控制感染性病原体。